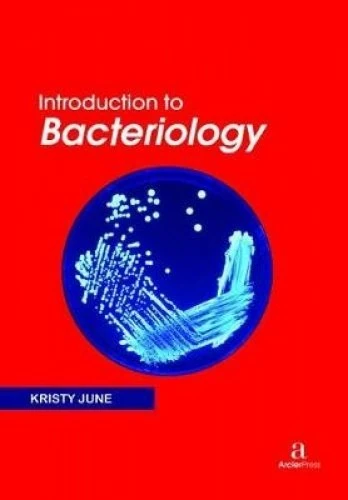
Introduction to Bacteriology

We can't find the internet
Attempting to reconnect
Something went wrong!
Hang in there while we get back on track

£94.83
Introduction to Nanomaterials
Price data last checked 103 day(s) ago - refreshing...
We'll watch every seller, every day. One email when your price arrives.
This is the usual price. Wait for it to drop, or tell us your number.
£95 today · usual range £0–£0 · best ever £75
NEW HERE?
Amazon shows you one price. We show you all of them.
Tosheroon watches Amazon prices so you don't have to. Every product on Amazon has a price history — we make it visible. Set the price you'd actually pay, and we'll email you the second it gets there. No app, no account, one email.
WHAT'S ON THIS PAGE
when this has been cheap or pricey
where the price is heading next
all-time high & low, recent range
name your number, we'll email you
Price History & Forecast
Grey patches = out of stock. Cheaper = lower on the chart. Hover for exact prices.
Last 545 days • 545 data points (No recent data available)
Price Distribution
Price distribution over 545 days • 4 price ranges
Price Analysis
Most common range: £83-91 (193 days, 35.4%)
Price range: £75 - £116
Price levels: 4 price ranges over 545 days
Product Specifications
- Format
- Hardcover
- ASIN
- 1774690527
- Domain
- Amazon UK
- Release Date
- 30 December 2021
- Listed Since
- 23 October 2021
Barcode
No barcode data available
Similar Products You Might Like

Introduction to Functional Nanomaterials

Introduction to Biophysical Chemistry by Arcler Press

Introduction to Computational Geometry

Encyclopedia of Nanotechnology

Introduction to Microprocessors

Introduction to Food Engineering

Applications of Nanowires in Electronics

Introduction to Enzymology

An Introduction to Cold and Ultracold Chemistry
Introduction to Bacteriology

Introductory Biology

Fundamentals of Motion: Introduction to Classical Mechanics

Introduction to Cell Biology

An Introduction to Genetics

Discrete Mathematics: An Introduction

Nonlinear & Complex Systems

Engineering Materials

Photonic Crystals - Introduction, Theory and Applications

Introduction to Virtual Reality

Applications of Conductive Polymers

Fundamentals of Power Electronics

Wave Motion and Applied Science

Introduction to Biostatistics using R
